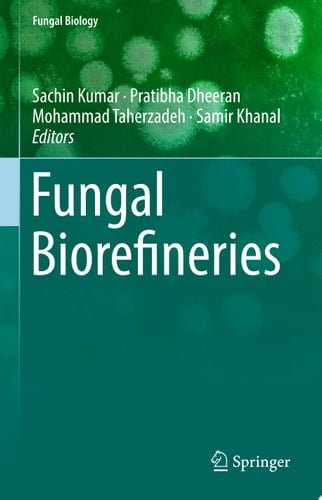
Fungal Biorefineries

This book covers the applications of fungi used in biorefinery technology. As a great many different varieties of fungal species are available, the text focuses on the various applications of fungi for production of useful products including organic acids (lactic, citric, fumaric); hydrolytic enzymes (amylase, cellulases, xylanases, ligninases, lipases, pectinases, proteases); advanced biofuels (ethanol, single cell oils); polyols (xylitol); single cell protein (animal feed); secondary metabolites; and much more.
Page Count:
246
Publication Date:
2018-07-04
ISBN-10:
3319903799
ISBN-13:
9783319903798
No comments yet. Be the first to share your thoughts!